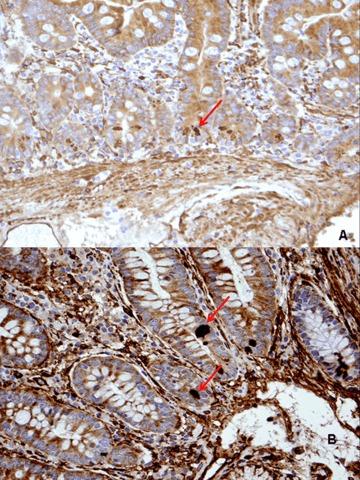
https://cdn.ncbi.nlm.nih.gov/pmc/blobs/f0ee/3823359/96b8b9184b76/jcmm0013-0334-f4.jpg

乳糜泻中黏膜组织转谷氨酰胺酶的表达
Mucosal tissue transglutaminase expression in celiac disease.
作者信息
Villanacci Vincenzo, Not Tarcisio, Sblattero Daniele, Gaiotto Tiziano, Chirdo Fernando, Galletti Anna, Bassotti Gabrio
机构信息
Second Pathology Department, Spedali Civili, Brescia, Italy.
出版信息
J Cell Mol Med. 2009 Feb;13(2):334-40. doi: 10.1111/j.1582-4934.2008.00325.x. Epub 2008 Mar 28.
Tissue transglutaminase (tTG) plays an important role in celiac disease pathogenesis and antibodies to tTG are a diagnostic marker of gluten-sensitive enteropathy. The aim of this study was to investigate the localization of tTG in the duodenal mucosa in control tissues and in different histological stages of celiac disease by using a commercial and a novel set of anti-tTG monoclonal antibodies, to see whether this assessment can be useful for diagnostic purpose. The distribution of tTG was firstly evaluated in 18 untreated celiac patients by using a commercial monoclonal antibody (CUB7402) against tissue transglutaminase enzyme and directed against the loop-core region of the enzyme. Thereafter, in further 30 untreated celiac patients we employed three newly characterized anti-tTG monoclonal antibodies produced against recombinant human-tTG. The epitopes recognized are located in three distinct domains of the protein corresponding to the core, C1 and C2 protein structure. Eleven age- and sex-matched patients with chronic duodenitis acted as controls. All subjects underwent upper endoscopy to obtain biopsy samples from the duodenum. Overall, we found that (i) tTG is equally expressed in CD at different stages of disease; (ii) tTG is expressed, at similar level, in CD and controls with duodenitis. Assessment of tTG level in biopsy samples by immunohistochemical methods is not useful in the clinical diagnostic work-up of CD.
组织转谷氨酰胺酶(tTG)在乳糜泻发病机制中起重要作用,抗tTG抗体是麸质敏感性肠病的诊断标志物。本研究的目的是通过使用一种商用和一组新型抗tTG单克隆抗体,研究tTG在对照组织以及乳糜泻不同组织学阶段十二指肠黏膜中的定位,以观察这种评估是否对诊断有帮助。首先,使用一种针对组织转谷氨酰胺酶且靶向该酶环-核心区域的商用单克隆抗体(CUB7402),对18例未经治疗的乳糜泻患者的tTG分布进行评估。此后,在另外30例未经治疗的乳糜泻患者中,我们使用了三种新鉴定的针对重组人tTG产生的抗tTG单克隆抗体。所识别的表位位于蛋白质对应于核心、C1和C2蛋白质结构的三个不同结构域中。11例年龄和性别匹配的慢性十二指肠炎症患者作为对照。所有受试者均接受上消化道内镜检查以获取十二指肠活检样本。总体而言,我们发现:(i)tTG在疾病不同阶段的乳糜泻中表达水平相当;(ii)tTG在乳糜泻患者和十二指肠炎症对照患者中的表达水平相似。通过免疫组织化学方法评估活检样本中的tTG水平对乳糜泻的临床诊断检查并无帮助。